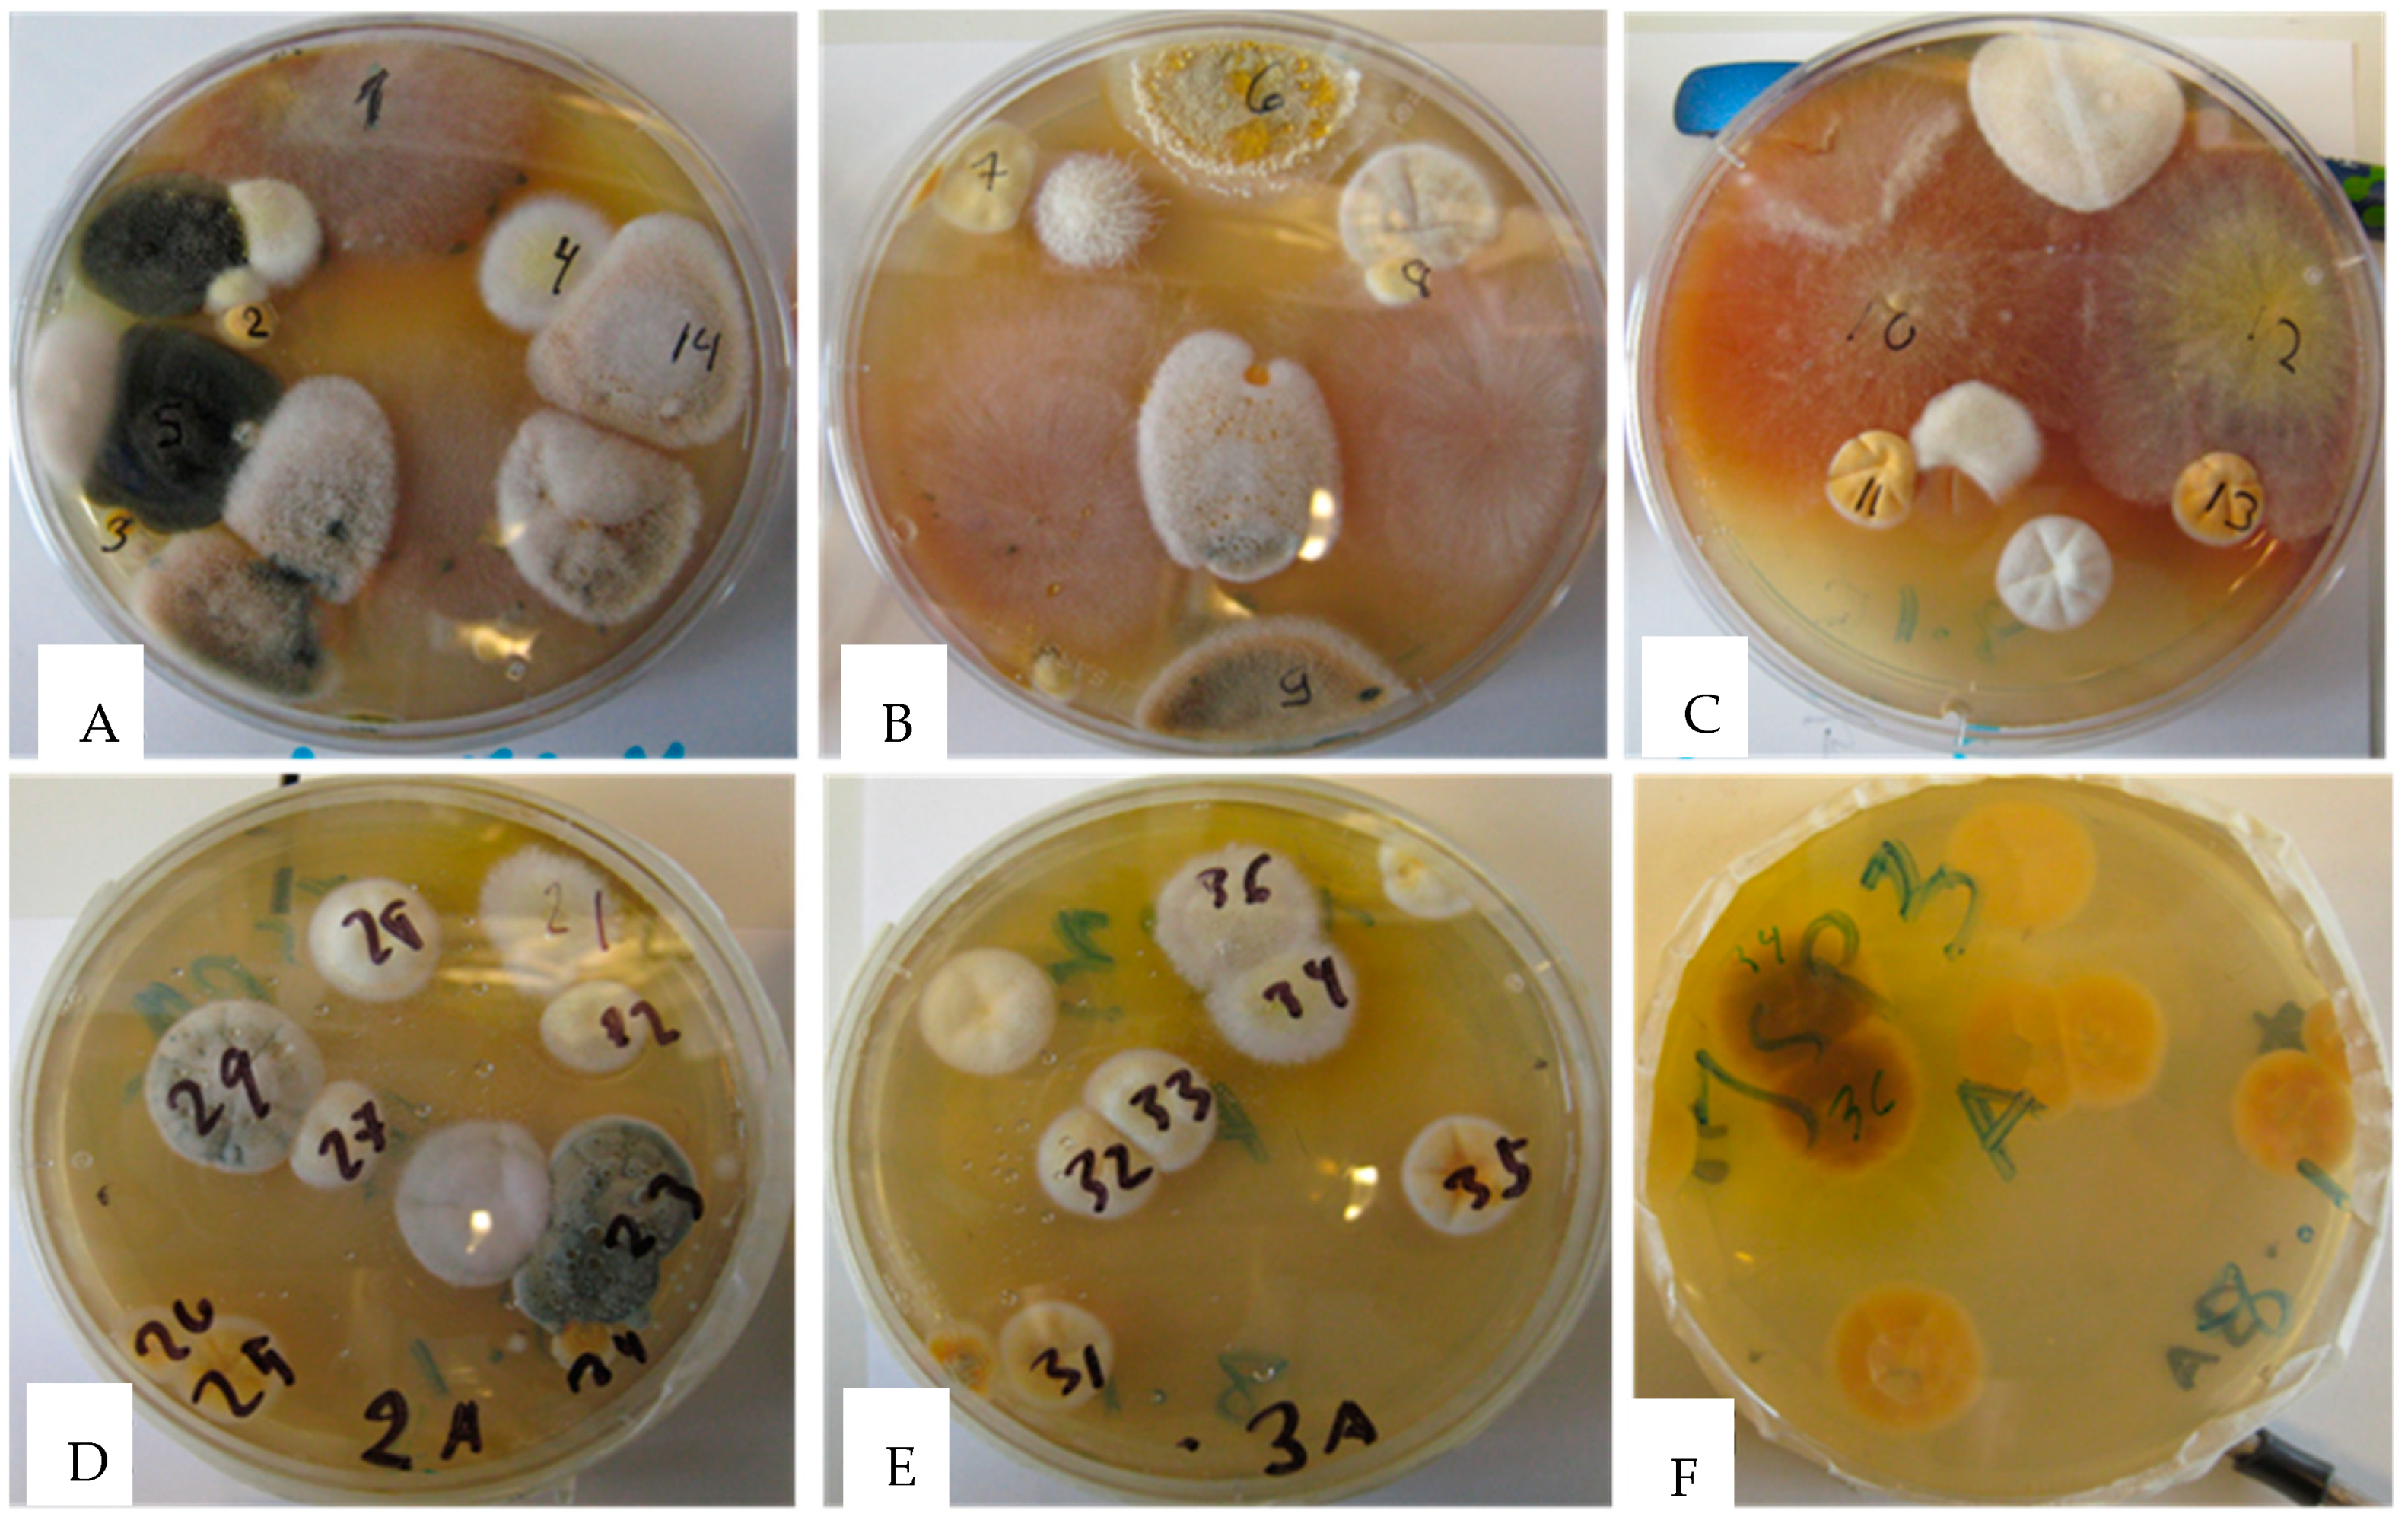
Toxins 11 00683 g001 Toxins 11 00683 g001
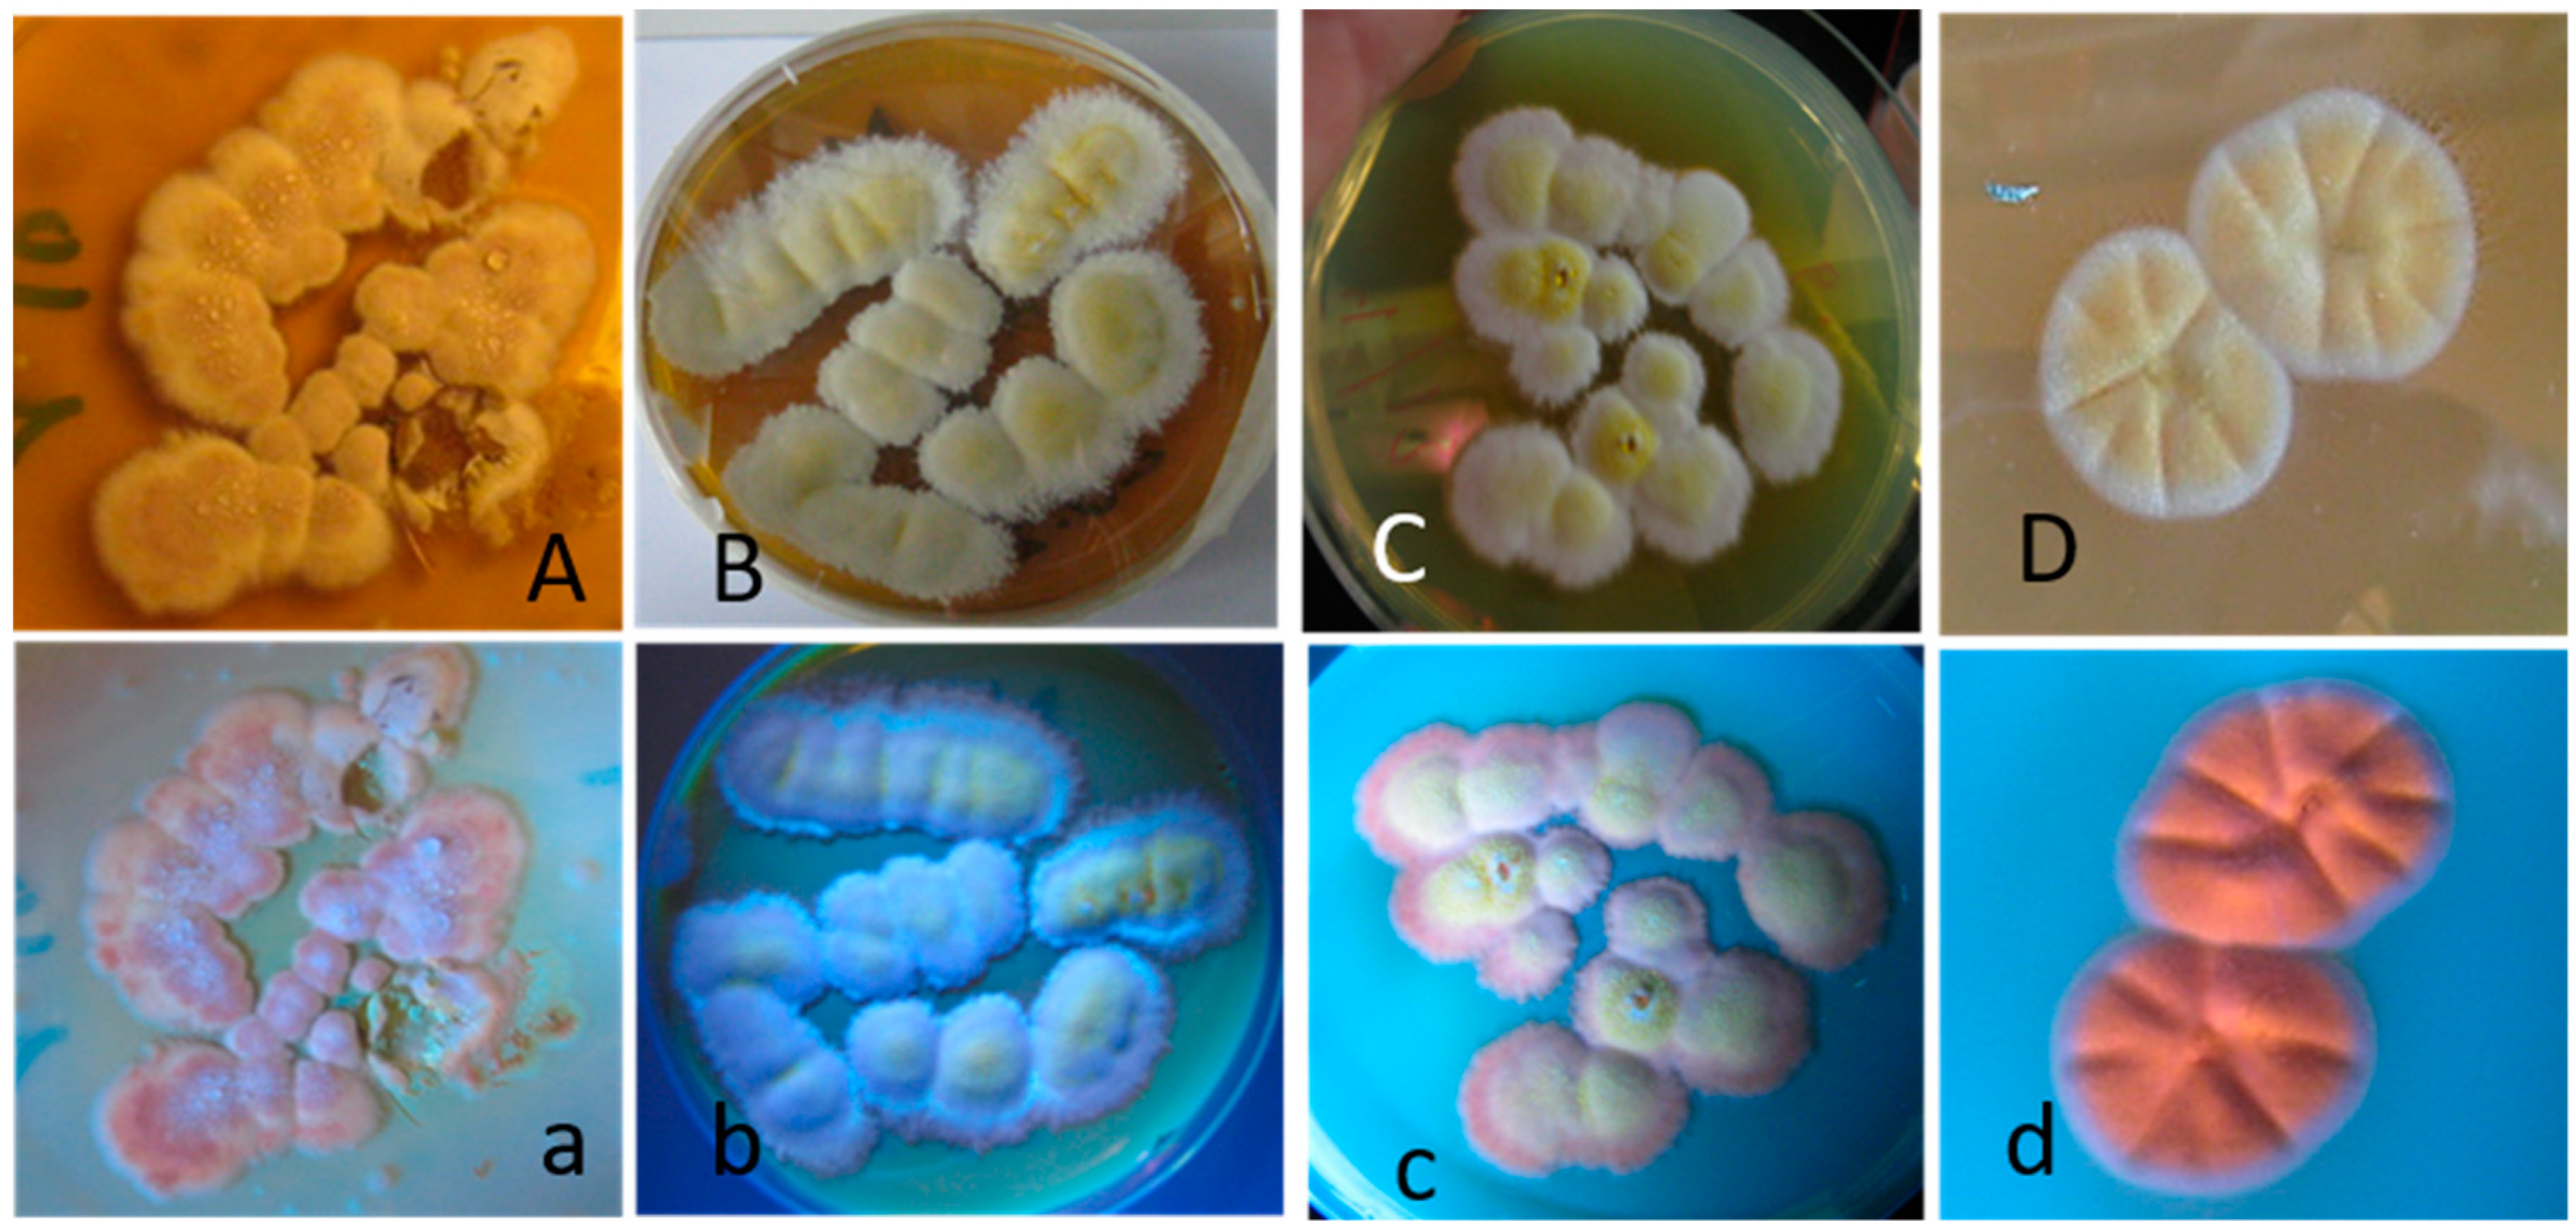
Toxins 11 00683 g003 Toxins 11 00683 g003

Screening Mold Colonies by Using Two Toxicity Assays Revealed Indoor Strains of Aspergillus calidoustus Producing Ophiobolins G and K
Abstract
1. Introduction
2. Results
2.1. Screening Single Colonies for Toxicity in Two Bioassays Divided Yellow–White Aspergillus Colonies in Two Categories Differing in Toxic Responses and Fluorescence Emission
2.2. The Four Blue-Fluorescing Strains Exhibited a Uniform Toxicity Profile in Four Bioassays and Were Identified as Aspergillus calidoustus
2.3. Toxic Compounds in the Crude Extract of Aspergillus calidoustus Were Identified as Ophiobolins
2.4. The Crude Extract of Aspergillus calidoustus Strain MH34 Provoked Sublethal Toxic Effects in Exposed Sperm Cells and Somatic Cells
3. Discussion
4. Conclusions
5. Materials and Methods
5.1. Experimental Design
5.2. Cultivation of Mold Colonies
5.3. Rapid Screening Tests with Ex Vivo and In Vitro Assays
5.4. Toxicity Assays for Ethanol-Soluble Dry Substances Extracted from a Plate-Grown Fungal Biomass and Pure Mycotoxins
5.5. Calculation of EC50, the Half Maximal Effective Concentrations for the Ethanol Dry Substances and Pure Mycotoxins in the BSMI, SMID, and ICP Assays
5.6. Fluorescence Microscopy
5.7. Identification of the Fungal Strains
5.8. Purification of Ophiobolin A
5.9. HPLC-MS Analysis and Identification of Mycotoxins in the Fungal Extracts
5.10. Reagents and Supplies
Author Contributions
Funding
Acknowledgments
Conflicts of Interest
References
- Samson, R.; Hoekstra, E.; Frisvad, J. (Eds.) Introduction to Food and Airborne Fungi, 7th ed.; CentraalbBureau voor Schimmelcultures: Utrecht, The Netherlands, 2004; pp. 483–484. [Google Scholar]
- Slack, G.J.; Puniani, E.; Frisvad, J.C.; Samson, R.A.; Miller, J.D. Secondary metabolites from Eurotium species, Aspergillus calidoustus and A. insuetus common in Canadian homes with a review of their chemistry and biological activity. Mycol. Res. 2009, 113, 480–490. [Google Scholar] [CrossRef] [PubMed]
- Samson, R.A.; Varga, J.; Meijer, M.; Frisvad, J.C. New taxa in Aspergillus section Usti. Stud. Mycol. 2011, 69, 81–97. [Google Scholar] [CrossRef] [PubMed]
- Hageskal, G.; Kristensen, R.; Fristad, R.F.; Skaar, I. Emerging pathogen Aspergillus calidoustus colonizes water distribution systems. Med. Mycol. 2011, 49, 588–593. [Google Scholar] [CrossRef] [PubMed]
- Nielsen, K.F.; Gravesen, S.; Nielsen, P.A.; Andersen, B.; Thrane, U.; Frisvad, J.C. Production of mycotoxins on artificially and naturally infested building materials. Mycopathologia 1999, 145, 43–56. [Google Scholar] [CrossRef]
- Nielsen, K.F.; Holm, G.; Uttrup, L.P.; Nielsen, P.A. Mold growth on building materials under low water activities. Influence of humidity and temperature on fungal growth and secondary metabolism. Int. Biodeterior. Biodegrad. 2004, 54, 325–336. [Google Scholar] [CrossRef]
- Varga, J.; Houbraken, J.; Van der Lee, H.A.L.; Verweij, P.E.; Samson, R.A. Aspergillus calidoustus sp. nov., causative agent of human infections previously assigned to Aspergillus ustus. Eukaryot. Cell 2008, 7, 630–638. [Google Scholar] [CrossRef]
- Wang, Q.X.; Yang, J.L.; Qi, Q.Y.; Bao, L.; Yang, X.L.; Liu, M.M.; Huang, P.; Zhang, L.X.; Chen, J.L.; Cai, L.; et al. 3-Anhydro-6-hydroxy-ophiobolin A, a new sesterterpene inhibiting the growth of methicillin-resistant Staphylococcus aureus and inducing the cell death by apoptosis on K562, from the phytopathogenic fungus Bipolaris oryzae. Bioorg. Med. Chem. Lett. 2013, 23, 3547–3550. [Google Scholar] [CrossRef]
- Wei, H.; Itoh, T.; Kinoshita, M.; Nakai, Y.; Kurotaki, M.; Kobayashi, M. Cytotoxic sesterterpenes, 6-epi-ophiobolin G and 6-epi-ophiobolin N, from marine derived fungus Emericella variecolor GF10. Tetrahedron 2004, 60, 6015–6019. [Google Scholar] [CrossRef]
- Bury, M.; Novo-Uzal, E.; Andolfi, A.; Cimini, S.; Wauthoz, N.; Heffeter, P.; Lallemand, B.; Avolio, F.; Delporte, C.; Cimmino, A.; et al. Ophiobolin A, a sesterterpenoid fungal phytotoxin, displays higher in vitro growth-inhibitory effects in mammalian than in plant cells and displays in vivo antitumor activity. Int. J. Oncol. 2013, 43, 575–585. [Google Scholar] [CrossRef]
- De Carvalho, C.R.; Vieira Mde, L.; Cantrell, C.L.; Wedge, D.E.; Alves, T.M.; Zani, C.L.; Pimenta, R.S.; Sales Junior, P.A.; Murta, S.M.; Romanha, A.J.; et al. Biological activities of ophiobolin K and 6-epi-ophiobolin K produced by the endophytic fungus Aspergillus calidoustus. Nat. Prod. Res. 2016, 30, 478–481. [Google Scholar] [CrossRef]
- Pósa, A.; Szabó, R.; Szalai, Z.; Kupai, K.; Deim, Z.; Murlasits, Z.; Bencsik, O.; Szekeres, A.; Vágvölgyi, C.; Balogh, L.; et al. The effect of acute ophiobolin A treatment on HO-mediated inflammatory processes. Hum. Exp. Toxicol. 2017, 36, 594–602. [Google Scholar] [CrossRef]
- Kildgaard, S.; Mansson, M.; Dosen, I.; Klitgaard, A.; Frisvad, J.C.; Larsen, T.O.; Nielsen, K.F. Accurate dereplication of bioactive secondary metabolites from marine-derived fungi by UHPLC-DAD-QTOFMS and a MS/HRMS library. Mar. Drugs 2014, 12, 3681–3705. [Google Scholar] [CrossRef]
- Bencsik, O.; Papp, T.; Berta, M.; Zana, A.; Forgó, P.; Dombi, G.; Andersson, M.A.; Salkinoja-Salonen, M.; Vágvölgyi, C.; Szekeres, A. Ophiobolin A from Bipolaris oryzae perturbs motility and membrane integrities of porcine sperm and induces cell death on mammalian somatic cell lines. Toxins 2014, 6, 2857–2871. [Google Scholar] [CrossRef] [PubMed]
- Mikkola, R.; Andersson, M.A.; Hautaniemi, M.; Salkinoja-Salonen, M.S. Toxic indole alkaloids avrainvillamide and stephacidin B produced by a biocide tolerant indoor mold Aspergillus westerdijkiae. Toxicon 2015, 99, 58–67. [Google Scholar] [CrossRef] [PubMed]
- Salo, M.J.; Marik, T.; Mikkola, R.; Andersson, M.A.; Kredics, L.; Salonen, H.; Kurnitski, J. Penicillium expansum strain isolated from indoor building material was able to grow on gypsum board and emitted guttation droplets containing chaetoglobosins and communesins A, B and D. J. Appl. Microbiol. 2019, 127, 1135–1147. [Google Scholar] [CrossRef] [PubMed]
- Castagnoli, E.; Marik, T.; Mikkola, R.; Kredics, L.; Andersson, M.A.; Salonen, H.; Kurnitski, J. Indoor Trichoderma strains emitting peptaibols in guttation droplets. J. Appl. Microbiol. 2018, 125, 1408–1422. [Google Scholar] [CrossRef]
- Castagnoli, E.; Salo, J.; Toivonen, M.S.; Marik, T.; Mikkola, R.; Kredics, L.; Vicente-Carrillo, A.; Nagy, S.; Andersson, M.T.; Andersson, M.A.; et al. An evaluation of boar spermatozoa as a biosensor for the detection of sublethal and lethal toxicity. Toxins 2018, 10, 463. [Google Scholar] [CrossRef]
- Andersson, M.A.; Mikkola, R.; Raulio, M.; Kredics, L.; Maijala, P.; Salkinoja-Salonen, M.S. Acrebol, a novel toxic peptaibol produced by an Acremonium exuviarum indoor isolate. J. Appl. Microbiol. 2009, 106, 909–923. [Google Scholar] [CrossRef]
- Mikkola, R.; Andersson, M.A.; Grigoriev, P.; Teplova, V.V.; Saris, N.-E.; Rainey, F.A.; Salkinoja-Salonen, M.S. Bacillus amyloliquefaciens strains isolated from moisture-damaged buildings produced surfactin and a substance toxic to mammalian cells. Arch. Microbiol. 2004, 181, 314–323. [Google Scholar] [CrossRef]
- Rasimus, S.; Mikkola, R.; Andersson, M.A.; Teplova, V.V.; Venediktova, N.; Ek-Kommonen, C.; Salkinoja-Salonen, M. Psychrotolerant Paenibacillus tundrae isolates from barley grains produce new cereulide-like depsipeptides (paenilide and homopaenilide) that are highly toxic to mammalian cells. Appl. Environ. Microbiol. 2012, 78, 3732–3743. [Google Scholar] [CrossRef]
- Rasimus-Sahari, S.; Teplova, V.V.; Andersson, M.A.; Mikkola, R.; Kankkunen, P.; Matikainen, S.; Gahmberg, C.G.; Andersson, L.C.; Salkinoja-Salonen, M. The peptide toxin amylosin of Bacillus amyloliquefaciens from moisture-damaged buildings is immunotoxic, induces potassium efflux from mammalian cells, and has antimicrobial activity. Appl. Environ. Microbiol. 2015, 81, 2939–2949. [Google Scholar] [CrossRef] [PubMed]
- Fujiwara, H.; Matsunaga, K.; Kumagai, H.; Ishizuka, M.; Ohizumi, A. Ophiobolin A, a novel apoptosis-inducing agent from fungus strain f-7438. Pharmacol. Commun. 2000, 6, 427–431. [Google Scholar] [CrossRef]
- Krizsán, K.; Bencsik, O.; Nyilasi, I.; Galgóczy, L.; Vágvölgyi, C.; Papp, T. Effect of the sesterterpene-type metabolites, ophiobolins A and B, on zygomycetes fungi. FEMS Microbiol. Lett. 2010, 313, 135–140. [Google Scholar] [CrossRef]
- Yang, T.; Lu, Z.; Meng, L.; Wei, S.; Hong, K.; Zhu, W.; Huang, C. The novel agent ophiobolin O induces apoptosis and cell cycle arrest of MCF-7 cells through activation of MAPK signaling pathways. Bioorg. Med. Chem. Lett. 2012, 22, 579–585. [Google Scholar] [CrossRef] [PubMed]
- Bury, M.; Girault, A.; Mégalizzi, V.; Spiegl-Kreinecker, S.; Mathieu, V.; Berger, W.; Evidente, A.; Kornienko, A.; Gailly, P.; Vandier, C.; et al. Ophiobolin A induces paraptosis-like cell death in human glioblastoma cells by decreasing BKCa channel activity. Cell Death Dis. 2013, 4, 561–572. [Google Scholar] [CrossRef]
- Vicente-Carrillo, A.; Edebert, I.; Garside, H.; Cotgreave, I.; Rigler, R.; Loitto, V.; Magnusson, K.E.; Rodríguez-Martínez, H. Boar spermatozoa successfully predict mitochondrial modes of toxicity: Implications for drug toxicity testing and the 3Rprinciples. Toxicol. In Vitro 2015, 29, 582–591. [Google Scholar] [CrossRef]
- Anoopkumar-Dukie, S.; Carey, J.B.; Conere, T.; O’Sullivan, E.; Van Pelt, F.N.; Allshire, A. Resazurin assay of radiation response in cultured cells. Br. J. Radiol. 2005, 78, 945–947. [Google Scholar] [CrossRef]
- Kruglov, A.G.; Andersson, M.A.; Mikkola, R.; Roivainen, M.; Kredics, L.; Saris, N.-E.; Salkinoja-Salonen, M.S. Novel mycotoxin from Acremonium exuviarum is a powerful inhibitor of the mitochondrial respiratory chain complex III. Chem. Res. Toxicol. 2009, 9, 565–573. [Google Scholar] [CrossRef]
- Ajao, C.; Andersson, M.A.; Teplova, V.V.; Nagy, S.; Gahmberg, C.G.; Andersson, L.C.; Hautaniemi, M.; Kakasi, B.; Roivainen, M.; Salkinoja-Salonen, M. Mitochondrial toxicity of triclosan on mammalian cells. Toxicol. Rep. 2015, 2, 624–637. [Google Scholar] [CrossRef]
- Mikkola, R.; Andersson, M.A.; Kredics, L.; Grigoriev, P.A.; Sundell, N.; Salkinoja-Salonen, M.S. 20-residue and 11-residue peptaibols from the fungus Trichoderma longibrachiatum are synergistic in forming Na+/K+-permeable channels and adverse action towards mammalian cells. FEBS J. 2012, 279, 4172–4190. [Google Scholar] [CrossRef]
- White, T.J.; Bruns, T.; Lee, S.; Taylor, J. Amplification and direct sequencing of fungal ribosomal RNA genes for phylogenetics. In PCR Protocols: A Guide to 574 Methods and Applications; Innis, M.A., Gelfand, D.H., Sninsky, J.J., White, T.J., Eds.; Academic Press: New York, NY, USA, 1990; pp. 315–322. [Google Scholar]
- Tischner, Z.; Kredics, L.; Marik, T.; Vörös, K.; Kriszt, B.; Péter, B.; Magyar, D. Environmental characteristics and taxonomy of microscopic fungi isolated from washing machines. Fungal Biol. 2019, 123, 650–659. [Google Scholar] [CrossRef] [PubMed]
- Mikkola, R.; Andersson, M.A.; Grigoriev, P.; Heinonen, M.; Salkinoja-Salonen, M.S. The toxic mode of action of cyclic lipodepsipeptide fusaricidins, produced by Paenibacillus polymyxa, toward mammalian cells. J. Appl. Microbiol. 2017, 123, 436–449. [Google Scholar] [CrossRef] [PubMed]

| EC50 µg mL−1 | ||||||
|---|---|---|---|---|---|---|
| Boar Sperm | PK-15 | |||||
| BSMI 1 | SMID 2 | ICP 2 | ||||
| 0.5–1 h | 1–2 days | 1 day | 2 days | |||
| A. calidoustus MH4 | 38 | 2 | 13 | 1 | ||
| A. calidoustus MH21 | 30 | 0.5 | 13 | 0.5 | ||
| A. calidoustus MH34 | 50 | 1 | 11 | 1 | ||
| A. calidoustus MH36 | 40 | 0.5 | 13 | 1 | ||
| Aspergillus sp. MH10 | >100 | 10 | >100 | 1 | ||
| Aspergillus sp. MH11 | >100 | 20 | >100 | 2 | ||
| Aspergillus sp. MH25 | >100 | 20 | >100 | 2 | ||
| Aspergillus sp. MH26 | >100 | 20 | >100 | 2 | ||
| Aspergillus sp. MH32 | >100 | 10 | >100 | 3 | ||
| Aspergillus sp. MH33 | >100 | 20 | >100 | 1 | ||
| Aspergillus sp. MH35 | >100 | 20 | >100 | 1 | ||
| Reference Strains | Mycotoxin Produced | References | ||||
| A. westerdijkiae PP2 | 10 | 5 | >50 | 15 | Avrainvillamide Stephacidin B Ochratoxin A | [14] |
| A. versicolor SL/3 | 250 | 20 | >100 | 1 | Sterigmatocystin Averufin | [15] |
| B. oryzae SZMC 13003 | >25 | 5 | 6 | Ophiobolin A | [16] | |
| T. atroviride Tri335 | 10 | 3 | 3 | 30 | Trichorzianines | [15] |
| C. globosum HS1 | 10 | 5 | >20 | 50 | Chaetoglobosins | [17] |
| T. reesei DSM 768 3 | 250 | >50 | >50 | 500 | None | [17] |
| Reference Mycotoxins | References | |||||
| Alamethicin | 5 | 0.2 | 0.2 | 8 | [17] | |
| Avrainvillamide | 0.6 | 0.3 | >2 | 0.3 | [14] | |
| Ochratoxin A | >100 | >50 | >50 | >50 | [14] | |
| Ophiobolin A | 2.5 | 0.25 | 2 | 0.2 | [16] | |
| Stephacidin B | 0.5 | 0.2 | >2 | 0.2 | [14] | |
| Sterigmatocystin | >100 | >20 | >20 | 0.25 | [14] | |
© 2019 by the authors. Licensee MDPI, Basel, Switzerland. This article is an open access article distributed under the terms and conditions of the Creative Commons Attribution (CC BY) license (http://creativecommons.org/licenses/by/4.0/).
Share and Cite
Salo, M.J.; Marik, T.; Bencsik, O.; Mikkola, R.; Kredics, L.; Szekeres, A.; Andersson, M.A.; Salonen, H.; Kurnitski, J. Screening Mold Colonies by Using Two Toxicity Assays Revealed Indoor Strains of Aspergillus calidoustus Producing Ophiobolins G and K. Toxins 2019, 11, 683. https://doi.org/10.3390/toxins11120683
Salo MJ, Marik T, Bencsik O, Mikkola R, Kredics L, Szekeres A, Andersson MA, Salonen H, Kurnitski J. Screening Mold Colonies by Using Two Toxicity Assays Revealed Indoor Strains of Aspergillus calidoustus Producing Ophiobolins G and K. Toxins. 2019; 11(12):683. https://doi.org/10.3390/toxins11120683
Chicago/Turabian StyleSalo, Marja Johanna, Tamás Marik, Ottó Bencsik, Raimo Mikkola, László Kredics, András Szekeres, Maria A. Andersson, Heidi Salonen, and Jarek Kurnitski. 2019. "Screening Mold Colonies by Using Two Toxicity Assays Revealed Indoor Strains of Aspergillus calidoustus Producing Ophiobolins G and K" Toxins 11, no. 12: 683. https://doi.org/10.3390/toxins11120683
APA StyleSalo, M. J., Marik, T., Bencsik, O., Mikkola, R., Kredics, L., Szekeres, A., Andersson, M. A., Salonen, H., & Kurnitski, J. (2019). Screening Mold Colonies by Using Two Toxicity Assays Revealed Indoor Strains of Aspergillus calidoustus Producing Ophiobolins G and K. Toxins, 11(12), 683. https://doi.org/10.3390/toxins11120683








